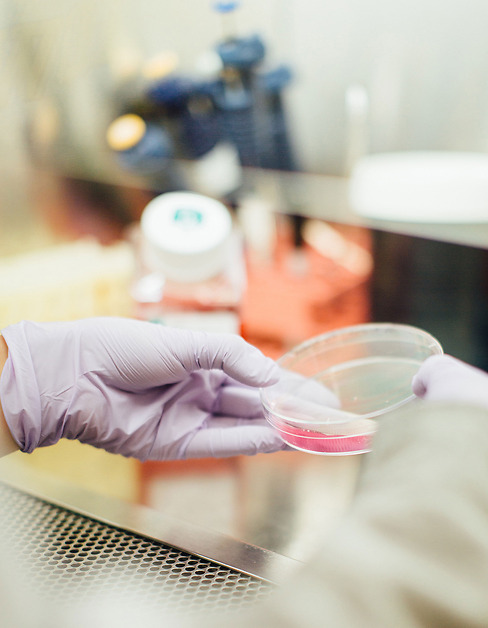
Patentprofylax

Vi skräddarsyr immaterialrättsliga lösningar perfekta för dina behov och förutsättningar. Till exempel:

En produkt, process eller tjänst kan ofta skyddas av flera olika typer av immaterialrättigheter, till exempel patent, varumärkesregistrering, och designskydd.
Ett patent ger dess innehavare ensamrätt att utnyttja den uppfinning som täcks av patentet. Ensamrätten innebär att innehavaren av patentet under en begränsad tid kan hindra andra att tillverka, sälja eller importera uppfinningen. Patentinnehavaren har därmed en konkurrensfördel, men är i gengäld skyldig att offentliggöra uppfinningen. Offentliggörandet hjälper andra att fortsätta utveckla uppfinningen och driver utvecklingen framåt.
Designregistering kan användas för att skydda utseendet av en produkt. Varumärkesregistrering kan användas för att ge formellt skydd för ett varumärke.
Vi hjälper dig att skydda din idé. Välkommen att kontakta oss.

En uppfinning måste uppfylla tre villkor för att vara patenterbar:
För att uppfylla villkoret på nyhet är det alltså viktigt att hålla sin uppfinning hemlig fram till ansökningsdagen. Detta innebär att den inte får ha publicerats, presenterats, eller använts någonstans i världen innan ansökan lämnats in.
Loppet behöver inte vara helt kört även om du råkat offentliggöra din uppfinning innan du lämnade in din patentansökan. En del länder tillämpar nämligen en så kallad grace period på upp till 12 månader efter att du offentliggjort din egen uppfinning. Det innebär att du inom denna period ändå kan lämna in en patentansökan i dessa länder utan att ditt offentliggörande anses vara ett nyhetshinder där.
Eftersom en patentansökan blir offentlig och ensamrätten endast gäller under en begränsad tid kan det ibland vara bättre att hålla sin uppfinning hemlig och inte söka patent. Detta passar dock endast för vissa typer av produkter och processer. Det finns dessutom alltid en risk att en hemlighet blir avslöjad.
En uppfinnare kan även överväga att publicera sin uppfinning och på så sätt hindra andra från att söka patent och få ensamrätt för samma teknik, eftersom tekniken då inte längre är ny och därmed inte patenterbar.
Vi är experter på att bedöma vilken väg som är bäst att gå.
Den som utan tillstånd från patentinnehavaren utnyttjar en uppfinning i ett land där den är patentskyddad begår intrång. Patentinnehavaren kan försöka få till en förhandlingslösning med den som begår intrånget eller bedriva frågan i domstol i det land där intrånget sker. Den som har ett patent är alltså skyddad mot att någon annan utnyttjar den patenterade tekniken utan lov. Användning i länder där uppfinningen inte har patentskydd kan däremot inte förhindras. Läs mer om hur vi kan hjälpa er med patentskydd
Ett patent är en nationell ensamrätt och måste sökas i varje land där man vill ha skydd. För att underlätta detta finns dock internationella avtal och regionala samarbeten.

Du kan lämna in din ansökan direkt i varje land där du önskar få skydd och betala de avgifter som krävs.
Till exempel kan du börja med en svensk ansökan som lämnas in till Patent- och Registreringsverket, PRV. Inom 12 månader från inlämningsdagen för den svenska ansökan, det s.k. prioritetsåret, kan du sedan gå vidare och lämna in samma ansökan i andra länder där du vill försöka skydda din uppfinning. Ansökan behandlas då i respektive land av den nationella patentmyndigheten där.
Vill du ha patent i flera europeiska länder kan det vara mer kostnadseffektivt att lämna in en patentansökan till det europeiska patentverket (EPO). EPO verkar som ett centralt patentverk för de europeiska länder som skrivit under överenskommelsen European Patent Convention, EPC. EPO granskar och prövar din patentansökan och meddelar sedan ett centralt beslut som erkänns av de länder som anslutit sig till EPC.
Om din ansökan blir beviljad patent av EPO, måste du fatta ett beslut om i vilka av de anslutna europeiska länderna du vill att patentet ska gälla och validera ditt patent i respektive land genom att betala vissa avgifter och i en del av länderna även lämna in en översättning av patentet.

Det finns en internationell överenskommelse, Patent Cooperation Treaty (PCT), som ger dig en internationell preliminär patenterbarhetsbedömning av din ansökan. Denna internationella väg kan väljas direkt för den första ansökan, eller inom 12 månader från inlämningen av en svensk eller europeisk ansökan.
Med den internationella vägen, kan du vänta tills 30 månader från det att den första ansökan lämnades in, innan du går vidare med ansökan till de länder där du vill skydda din uppfinning. Jämfört med den nationella vägen kan du alltså senarelägga beslutet om i vilka länder du vill söka patent. Det ger dig möjlighet att skjuta på de kostnader som uppkommer i samband med utlandsansökningar och mer tid att utvärdera din uppfinnings potential.
Genom PCT-förfarandet kan man söka patent i över 100 länder utifrån den internationella ansökan.
Patent beviljas, i Sverige och de flesta andra länder, för en tid av 20 år från inlämningsdagen. För vissa kategorier av uppfinningar, främst läkemedel, kan patenttiden förlängas ytterligare.

Normalt uppgår ett patentskydd till 20 år efter patentansökans inlämnande, men för läkemedel och växtskyddsmedel kan du ansöka om tilläggsskydd, Supplementary Protection Certificate (SPC), i de EU-länder där du erhållit ett patent. Ett tilläggsskydd kan förlänga skyddstiden för ett patenterat läkemedel eller växtskyddsmedel inom EU.
Ansökan om SPC kan endast göras efter utfärdande av ett marknadsgodkännande för en patentskyddad produkt. Tillläggsskyddet är begränsat till den aktiva föreningen eller de aktiva föreningarna i produkten och får inte redan tidigare ha meddelats för det aktuella läkemedlet eller växtskyddsmedlet. Tilläggsskydd kan inte meddelas för längre tid än 5 år.
Om tilläggsskyddet avser ett läkemedel och dess lämplighet för barn har undersökts i pediatriska studier, kan dock tilläggsskyddets giltighetstid förlängas med ytterligare 6 månader.
Vill du veta mer om tilläggsskydd är du välkommen att kontakta oss.

I USA är det möjligt att få en förlängning av patenttiden för en produkt som kräver ett myndighetsgodkännande innan den får säljas, som till exempel human- och veterinärläkemedel, färg- och livsmedelstillsatser, och medicintekniska produkter. Patenttiden kan även förlängas för patent som avser en metod för användning eller tillverkning av sådana produkter. Förlängningen kan uppgå till 5 år. Ytterligare 6 månader kan erhållas om läkemedlets lämplighet för barn har undersökts (pediatriska studier).
Välkommen att kontakta oss om du vill veta mer om förlängning av patenttiden i USA.
För att ett beviljat patent ska fortsätta vara i kraft måste regelbundna avgifter betalas till berörda patentmyndigheter i respektive land så länge du vill upprätthålla patentskyddet. När patentet gått ut kan andra inte längre hindras från att nyttja den patenterade tekniken. I en del länder måste årliga avgifter betalas även under ansökans handläggning.

Immateriella rättigheter kräver ofta stora investeringar och ibland krävs både snabba och effektiva åtgärder för att hävda dem.
När ett patent meddelats inträder i många länder en period då andra personer kan invända mot beviljandet. En invändning är ett tvistliknande förfarande som istället för domstol hanteras av patentmyndigheten i det aktuella landet eller regionen, som till exempel Patent- och registreringsverket (PRV), och Europeiska patentverket (EPO).
Resultatet av en invändning blir antingen att patentet upphävs, att invändningen avslås (patentet fortsätter att gälla) eller att patentet upprätthålls i ändrad lydelse.
Ett patent kan avsiktligt eller oavsiktligt bli utsatt för intrång. Förhoppningsvis kan detta lösas genom förlikningar och avtal och ofta kan talan om intrång väckas bara för att få motparten till förhandlingsbordet. I andra situationer leder patentintrång dock vidare till förhandling inför domstol. Vid patenttvister samarbetar vi i egenskap av tekniska biträden med jurister.
Innan man börjar utveckla, utnyttja eller marknadsföra en produkt, tjänst eller ett förfarande, är det klokt att först ha kontrollerat om det finns risk att göra intrång i andras patent eller om man kan komma att bli beroende eller begränsad av andras rättigheter.
Den aktuella situationen kan analyseras i en Freedom-To- Operate (FTO), eller market clearence-undersökning. Den innebär att vi gör sökningar i databaser för att hitta liknande patent och patentansökningar. Sedan analyserar vi dessa för att se om er produkt riskerar att falla innanför det skyddsomfång som definieras i dessa patent eller patentansökningar. Dessutom undersöker vi om de patent och ansökningar som kommer fram vid sökningen fortfarande är i kraft, eller fortfarande är under handläggning.
FTO-undersökningen avgränsas till de länder som är aktuella för er. Skulle ett hindrande patent påträffas kanske er produkt eller tjänst behöver ändras för att kringgå patentet eller så kan det bli nödvändigt att försöka erhålla en licens.

Inför en investering, försäljning, fusion eller förvärv av ett företag eller en verksamhet genomförs ofta en due diligence för att bedöma värdet och riskerna med investeringsobjektet.
IP Due Diligence innebär att vi synar ett bolags registrerade immateriella rättigheter. Vi sätter samman ett team och gör en systematisk undersökning, analys och dokumentering av rättigheterna av bolagets registrerade immaterialrätter.
Innan du ansöker om ett patent eller påbörjar utveckling av ny produkt är det bra om du först undersöker om din idé eller en produkt redan är känd eller skyddad av någon annan. Vi kan hjälpa till med nyhetsundersökningar för olika syften, till exempel om det finns andra lösningar som liknar din uppfinning, vilka konkurrenter du har, eller hur den senaste tekniken inom ett område ser ut.
För att göra en nyhetsundersökning behövs en beskrivning av det aktuella teknikområdet, en teknisk beskrivning av den nya idén eller produkten, eller på lydelsen hos de tänkta patentkraven, med väl tilltagen mariginal. Nyhetsundersökningen innebär sökning i databaser följt av en bedömning av det tekniska innehållet i det som hittas vid databassökningen.

Omvärldsbevakning kan hjälpa dig att förstå och förutse vad som sker inom ett teknikområde, och hos konkurrenterna. I samarbete med dig kan vi sätta upp en profil för att bevaka publicerade patent och patentansökningar inom ett specifikt teknikområde eller hos konkurrenter allteftersom de publiceras. Vi kan även sätta upp bevakningar för konkurrenternas lanseringar runt om i världen.
Misstänker du att någon gör ett intrång kan vi hjälpa dig att undersöka om den konkurrerande verksamheten eller produkten gör intrång i ditt patent.
Om en motpart påstår att din verksamhet eller produkt gör intrång i ett patent, undersöker vi på motsvarande sätt om din verksamhet eller produkt har särdrag som faller under det patentet.